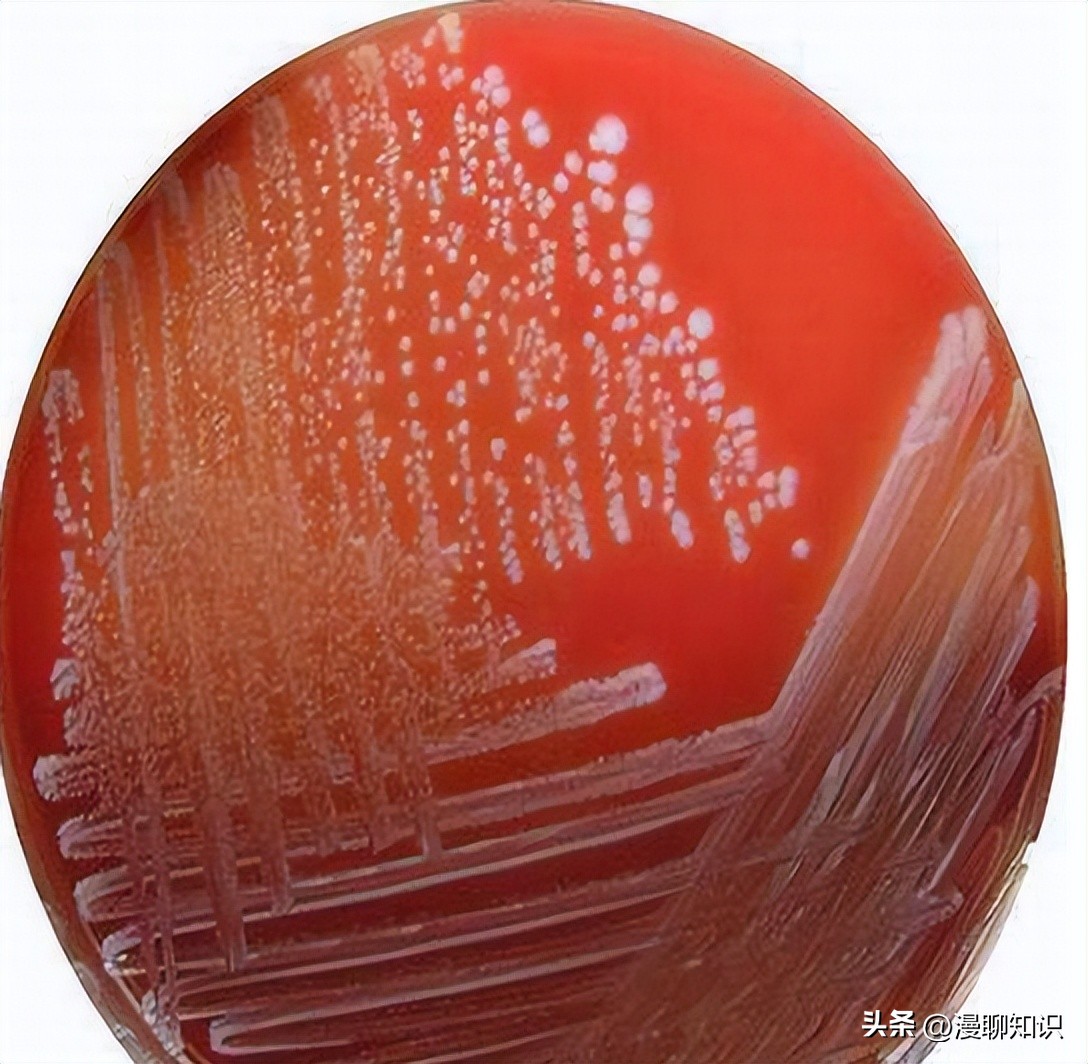
牦牛是高山地区牛的独特品种，肉质鲜嫩，但却饱受葡萄球菌的侵害

阅读文章前,辛苦您点下右上角的“关注”,方便您讨论分享,持续关注每日优质内容~
牦牛是高山地区牛的独特品种,生活在青藏高原,平均海拔3 000 m以上。
肉质鲜嫩,含丰富的微量元素,是促进*藏西**经济发展的重要产业。
葡萄球菌(Staphylococcus)在*藏西**牦牛群中广泛流行,且多数具有致病性;通过查阅相关文献资料发现,*藏西**对于牦牛葡萄球菌防治的报道较少,且随着近年来抗生素的滥用,葡萄球菌的耐药性越来越强,相关感染的诊治及预防也越来越棘手,所以对牦牛葡萄球菌感染的防治也越来越重要。

研究发现,从牛奶中分离出的凝固酶阴性葡萄球菌具有多种毒力因子,包括β-溶血素、肠毒素等,除能造成奶牛乳房炎外,产色葡萄球菌还能造成猪的渗出性皮炎,一些菌株还显示出对耐甲氧西林金黄色葡萄球菌(MRSA)等病原体的抗菌活性。
葡萄球菌是一种无鞭毛,一般不产生荚膜,不产生芽孢的革兰氏阳性球菌。
产色葡萄球菌(Staphylococcus chromogenes)属于凝固酶阴性葡萄球菌,现在已成为临床感染的重要病原菌,同时也是一种条件致病菌,可引起牛羊乳房炎、化脓性感染等疾病。
研究表明,凝固酶阴性葡萄球菌可使用疫苗进行预防,Vasileiou等[8]报道,试验条件下,接种疫苗的母羊乳腺炎持续时间较短,感染比例较小,组织病理学评分较低。
当前,对牦牛产色葡萄球菌的研究较少。
本研究从拉萨市不同地区随机采集65份样品,进行产色葡萄球菌分离鉴定,并研究其耐药性及致病性,以期为牦牛源产色葡萄球菌感染的药物筛选及治疗提供一定的参考。

2022年7月,从拉萨市不同地区随机采集健康牦牛鼻拭子25份,奶样40份,共65份。
6只雌性健康SPF级昆明小鼠,由*藏西**自治区兽医生物药品制造厂提供。
胰蛋白胨大豆琼脂(TSA)、胰蛋白胨大豆肉汤(TSB)均购自青岛海博生物技术有限公司;细菌基因组DNA提取试剂盒(DP-302)购自天根生化科技(北京)有限公司;葡萄球菌生化鉴定管、成套药敏纸片(30种)均购自杭州微生物试剂有限公司;0.9%氯化钠注射液购自陕西圣奥动物药业有限公司;无菌脱纤维绵羊血购自郑州诚睿生物科技有限公司;DL2000 DNA Marker、DL1000 DNA Marker均购自宝日医生物技术(北京)有限公司。

台式恒温振荡器(型号:BSD-TF270)、净化工作台(型号:BJ-2CD)、隔水式电热恒温培养箱(型号:BG-270)均购自上海*讯博**实业有限公司医疗设备厂;电泳仪(型号:041BR)购自Bio-Rad公司;凝胶成像系统(型号:JYD4S-3C)购自北京君意东方电泳设备有限公司;正置生物显微镜(型号:DM3000 LED)购自Leica公司;梯度PCR扩增仪(型号:Biometra Tone 96G)购自Analytik Jena AG公司。
将采集到的牦牛鼻拭子,无菌操作放入到含有5%胎牛血清的TSB培养液中,吸取200 μL奶样,接种到相同培养液中;置于摇床中37 ℃、120 r/min培养18 h,将菌液接种于5%绵羊血平板上,37 ℃恒温培养18 h,挑取单个菌落,反复纯化培养4代,进行革兰氏染色、镜检。

将纯化好的单个菌落,按照葡萄球菌属细菌生化鉴定管说明书,接种于生化试剂管中(新生霉素按说明进行药敏试验,用于凝固酶阴性葡萄球菌的鉴别),37 ℃恒温培养24 h,观察并记录试验结果。
利用细菌组DNA提取试剂盒提取分离菌株DNA,并以此为模板进行16S rDNA基因扩增。
16S rDNA通用引物序列为:F27:5′-AGAGTTTGATCCTGGCTCAG-3′;R1492:5′-TACGGCTACCTTGTTACGACTT-3′。
引物由生工生物工程(上海)股份有限公司合成。
PCR产物进行2.0%琼脂糖凝胶电泳检测,电泳完成后,将凝胶放入成像系统,观察并记录试验结果,PCR产物送往成都擎科生物技术有限公司进行测序。
将测序结果经BLAST进行比对分析,利用Mega 7.0软件构建系统发育树。

吸取200 μL纯化后的菌液,无菌操作均匀涂布于TSA平板(5%胎牛血清),选取氨苄西林、多黏菌素B、头孢曲松、四环素、新霉素、卡那霉素、庆大霉素、青霉素、头孢他啶、多西环素、丁胺卡那等19种常见抗菌药,利用纸片扩散法(K-B法),将药敏片均匀贴在涂完菌的平板上,37 ℃培养18 h,观察并记录试验结果。
试验结果参照美国临床实验室国家标准化委员会(NCCLS)制定的标准判定,个别参照杭州微生物试剂有限公司提供的药敏试验纸片法的抑菌范围解释标准。

6只小鼠分为2组,试验组和对照组,每组3只;在纯化后的血平板上,利用接种环,挑取单个菌落,接种到含5%胎牛血清的TSB培养液中,37 ℃恒温培养16 h;吸取培养好的菌液(3.5×108CFU/mL)腹腔注射试验组小鼠,0.5 mL/只,对照组小鼠腹腔注射等量无菌0.9%氯化钠注射液;观察7 d内小鼠状况,并记录试验结果。
将死亡小鼠沿腹线剪开,用灭菌的镊子及剪刀采集小鼠的心脏、肝脏、脾脏、肺脏、肾脏,依次放入装有4%甲醛溶液的玻璃瓶中固定,制成包埋切片,HE染色,显微镜下观察记录。

从采集的65份牦牛样品中分离到9株产色葡萄球菌疑似菌株,分别命名为XZ1~XZ9,总分离率为13.85%;其中,从鼻拭子中分离到1株,分离率为4.00%(1/25);从奶样中分离到8株,分离率为20.00%(8/40)。
9株分离菌在平板上光滑潮湿,边缘略整齐,中间有圆形突起的淡黄色不透明菌落;革兰氏染色后,镜检均为革兰氏阳性球菌,呈串珠状分布。
随机选取XZ1菌液进行生化试验,结果显示,分离菌株对甘露糖、果糖、蔗糖、硝酸盐还原4种生化试剂反应为阳性,对新生霉素高度敏感,符合产色葡萄球菌的生化特性,结合XZ1形态特征,可初步判定为产色葡萄球菌。

|
项目 Items |
结果 Results |
项目 Items |
结果 Results |
|
蕈糖Mushroom candy |
- |
乳糖Lactose |
- |
|
甘露醇Mannitol |
- |
麦芽糖Maltose |
- |
|
甘露糖Mannose |
+ |
蔗糖Maltose |
+ |
|
果糖Fructose |
+ |
尿素Urea |
- |
|
木糖Xylose |
- |
硝酸盐还原Nitrate reduction |
+ |
|
新生霉素敏感Novobiocin senstivity |
+ |

分别以分离菌XZ1~XZ9基因组作为模板,以16S rDNA通用引物进行PCR扩增,扩增出9条长度为1 500 bp的明亮目的条带,与预期大小相符。
将测序结果经BLAST进行比对分析,XZ1~XZ9与产色葡萄球菌相似性达96%以上。
利用Mega 11.0软件,采用NJ法构建系统发育树,XZ1~XZ9与GenBank收录的8株产色葡萄球菌聚在一起,XZ3与产色葡萄球菌MN314440.1的部分序列相似性为99.11%,且聚为1个小分支,亲缘关系较近。
XZ1~XZ8除XZ7外,与产色葡萄球菌MN314440.1、OP067948.1、MT072170.1、MN314443.1和MH392293.1聚成1个大分支;XZ7与产色葡萄球菌MN314456.1相似性达98.84%,亲缘关系较近,聚为1个小分支;XZ9与其他菌株有所差异,独为1支,但与产色葡萄球菌MT072170.1相似性为99.87%;综上,可判定XZ1~XZ9为产色葡萄球菌。

药敏试验结果显示,9株分离菌株最多对3种抗菌药耐药,最少对1种抗菌药耐药,分离菌株均对多西环素、卡那霉素、头孢曲松、头孢呋辛、四环素、环丙沙星、氧氟沙星、诺氟沙星、庆大霉素、氯霉素、丁胺卡那、克林霉素12种抗菌药高度敏感,对红霉素中度敏感。
|
抗菌药 Antibiotics |
纸片含量 Paper content/(μg/片) |
抑菌圈直径 IZD/mm |
结果 Results/% |
||||
|
R |
I |
S |
R |
I |
S |
||
|
多西环素 Doxycycline |
30 |
≤12 |
13~15 |
≥16 |
0 |
0 |
100.00(9/9) |
|
青霉素 Penicillin |
10 U |
≤28 |
- |
≥29 |
33.33(3/9) |
0 |
66.67(6/9) |
|
红霉素 Erythromycin |
15 |
≤13 |
14~22 |
≥23 |
0 |
100.00(9/9) |
0 |
|
卡那霉素 Kanamycin |
30 |
≤13 |
14~17 |
≥18 |
0 |
0 |
100.00(9/9) |
|
新霉素 Neomycin |
30 |
≤12 |
13~16 |
≥17 |
0 |
11.11(1/9) |
88.89(8/9) |
|
头孢曲松 Ceftriaxone |
30 |
≤13 |
14~20 |
≥21 |
0 |
0 |
100.00(9/9) |
|
头孢呋辛 Cefuroxime |
30 |
≤14 |
15~22 |
≥23 |
0 |
0 |
100.00(9/9) |
|
头孢他啶 Ceftazidime |
30 |
≤14 |
15~17 |
≥18 |
0 |
22.22(2/9) |
77.78(7/9) |
|
四环素 Tetracycline |
30 |
≤14 |
15~18 |
≥19 |
0 |
0 |
100.00(9/9) |
|
环丙沙星 Ciprofloxacin |
5 |
≤15 |
16~20 |
≥21 |
0 |
0 |
100.00(9/9) |
|
诺氟沙星 Norfloxacin |
10 |
≤12 |
13~16 |
≥17 |
0 |
0 |
100.00(9/9) |
|
氧氟沙星 Ofloxacin |
5 |
≤12 |
13~15 |
≥16 |
0 |
0 |
100.00(9/9) |
|
多黏菌素B Polymyxin B |
300 |
≤8 |
9~11 |
≥12 |
0 |
33.33(3/9) |
66.67(6/9) |
|
庆大霉素 Gentamicin |
10 |
≤12 |
13~14 |
≥15 |
0 |
0 |
100.00(9/9) |
|
氯霉素 Chloramphenicol |
30 |
≤12 |
13~17 |
≥18 |
0 |
0 |
100.00(9/9) |
|
氨苄西林 Ampicillin |
10 |
≤28 |
- |
≥29 |
44.44(4/9) |
0 |
55.56(5/9) |
|
复方新诺明 Compound sulfamethoxazole |
25 |
≤10 |
11~15 |
≥16 |
55.56(5/9) |
0 |
44.44(4/9) |
|
丁胺卡那 Butylamine Kana |
30 |
≤14 |
15~16 |
≥17 |
0 |
0 |
100.00(9/9) |
|
克林霉素 Clindamycin |
2 |
≤14 |
15~20 |
≥21 |
0 |
0 |
100.00(9/9) |

试验组3只小鼠均在注射后7 h内出现毛皮凌乱、扎堆、易受惊、食欲废绝等症状;第2天出现1只死亡小鼠,剖检该死亡小鼠,发现其肺脏发白有出血斑,肾脏肿大,肝脏发黑,肠道水肿,透亮膨大,并对其肺脏、肠道及肾脏的细菌进行分离培养,发现符合攻毒菌株的形态特征。
在第3天处死、剖检试验组剩余2只小鼠中的1只,发现其肺脏发白,有瘀血斑,肾脏肿大,病变特征与死亡小鼠相似,对其肾脏、肠道及脾脏的细菌进行分离培养,经染色镜检发现也符合攻毒菌株的形态特征;7 d后剩余1只小鼠状态恢复正常,对照小鼠状态均保持正常。

组织病理切片结果显示,死亡小鼠肺脏组织呈弥漫性出血,血管充血,可见炎性细胞,渗出液,实质细胞变性坏死,部分肺泡囊融合形成腔体;肝细胞结构排列无明显异常,汇管区小叶间动脉充血,胆小管内充满血液,结缔组织增厚。
部分肾近曲小管内充满血液,肾小球囊腔增大,肾小管上皮细胞轻度空泡变性,刷毛边缘脱落,细胞扁平,管腔扩张;心肌细胞排列整齐,细胞核形态正常,心肌出血。

牦牛是高原地区独有的特殊牛种,是农牧民重要的经济来源之一,因其生长在高寒地区,生长缓慢,所以其肉质鲜嫩,皮毛厚实,是藏族人民赖以生存的物质基础,牦牛在*藏西**不仅具有一定的食用价值,也具有相当的运输能力,藏区人民的生活离不开牦牛。
因此,应对牦牛的疫病防控给予足够的重视,结合*藏西**地区的实际发展情况,提高牦牛养殖技术及疫病防控技术。

产色葡萄球菌是一种凝固酶阴性葡萄球菌,属于条件性病原菌,可分为无毒力型与有毒力型2种,肠毒素是其主要的致病因子,凝固酶阴性葡萄球菌是引起奶牛乳腺内感染的主要病原体,根据相关研究结果,产色葡萄球菌可感染多种动物,临床上猪感染以渗出性皮炎为主,家禽感染多呈现出关节炎症状,牛、羊感染则在临床上多以乳腺炎为主,人感染后可导致败血症及多器官功能衰竭。
本试验从拉萨各地区共采集健康牦牛样品65份,共分离出9株疑似菌株,经16S rDNA测序,BLAST分析比对结果显示,分离株与产色葡萄球菌相似性达96%以上,可确定为产色葡萄球菌,其分离率为13.85%。

其中,鼻拭子分离出1株,分离率为4.00%(1/25);奶样中分离出8株,分离率为20.00%(8/40),在奶样中较易分离到该菌株,这与王秋东等[19]2017年报道的内蒙古部分地区牛奶样中产色葡萄球菌的分离率为6.97%的结果有所差异,可能是与地域不同、奶牛品种不同以及养殖方式不同有关。
分离菌株在绵羊血琼脂平板上呈不溶血、淡黄色、光滑湿润、圆形隆起,与傅冬梅等分离到的产色葡萄球菌在血平皿上呈白色、圆形、边缘整齐、光滑、湿润、隆起、不溶血菌落,除菌落颜色不一致外基本相符,可能是由于培养基的营养物质有一定的差异性所导致。
此次试验采用分离菌株XZ1对小鼠进行攻毒,攻毒剂量为3.5×108 CFU/mL,小鼠出现死亡,对小鼠有较强的致病性;但送检牦牛并未发病,可能与个体不同且产色葡萄球菌为机会致病菌有关。
刘金凤等、费育超等研究结果显示,产色葡萄球菌的致病性低,且在正常小鼠中不致病;但赵霞玲等研究显示,其剂量为3.5×109 CFU/mL时,小鼠死亡率达100%。
本试验分离的9株产色葡萄球菌大都对复方新诺明耐药,耐药率达55.56%,对青霉素耐药率为33.33%,均对红霉素中度敏感,对多西环素、卡那霉素、头孢曲松等12种抗菌药高度敏感。

Regecová等对从羊乳及奶酪中分离到的产色葡萄球菌进行耐药性检测,其结果显示,分离到的菌株对青霉素、四环素和苯唑西林的耐药率最高,分别为95%、86%和81%,对庆大霉素的敏感性最高,为55%;赵德军等报道,从人乳腺分泌物分离到的1株产色葡萄球菌对青霉素、红霉素、诺氟沙星等敏感;可能是由于用药习惯不同及动物品种不同所导致的耐药情况不同。
在拉萨地区临床治疗牦牛产色葡萄球菌感染的过程中,可以参考本试验,结合实际情况,有针对性地选药用药。
本试验在65份牦牛样品*共中**分离出9株产色葡萄球菌,分离菌可同时耐多种药物;致病性较强,可致小鼠多器官病变,本试验结果可为拉萨地区牦牛源产色葡萄球菌的防治提供一定参考。